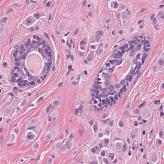
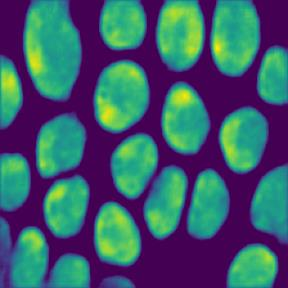
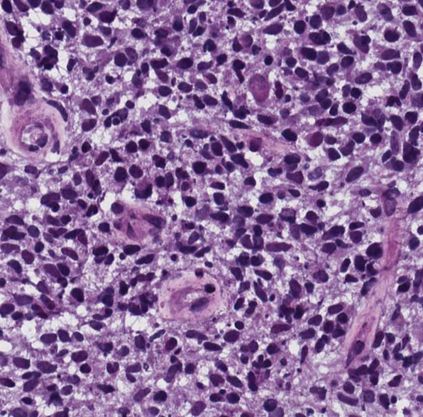

Microscopic image segmentation is a challenging task, wherein the objective is to assign semantic labels to each pixel in a given microscopic image. While convolutional neural networks (CNNs) form the foundation of many existing frameworks, they often struggle to explicitly capture long-range dependencies. Although transformers were initially devised to address this issue using self-attention, it has been proven that both local and global features are crucial for addressing diverse challenges in microscopic images, including variations in shape, size, appearance, and target region density. In this paper, we introduce SA2-Net, an attention-guided method that leverages multi-scale feature learning to effectively handle diverse structures within microscopic images. Specifically, we propose scale-aware attention (SA2) module designed to capture inherent variations in scales and shapes of microscopic regions, such as cells, for accurate segmentation. This module incorporates local attention at each level of multi-stage features, as well as global attention across multiple resolutions. Furthermore, we address the issue of blurred region boundaries (e.g., cell boundaries) by introducing a novel upsampling strategy called the Adaptive Up-Attention (AuA) module. This module enhances the discriminative ability for improved localization of microscopic regions using an explicit attention mechanism. Extensive experiments on five challenging datasets demonstrate the benefits of our SA2-Net model. Our source code is publicly available at \url{https://github.com/mustansarfiaz/SA2-Net}.
翻译:暂无翻译